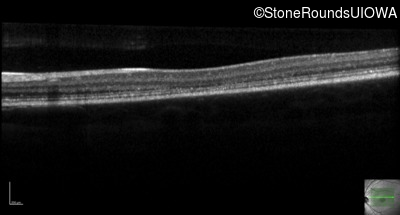
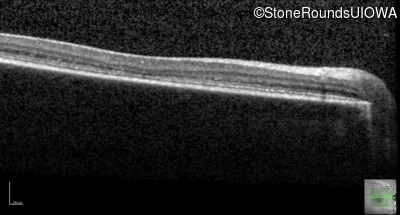
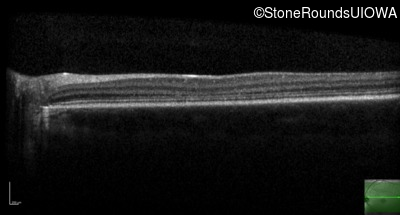
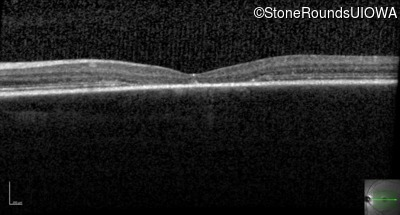
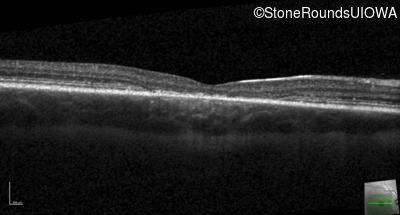
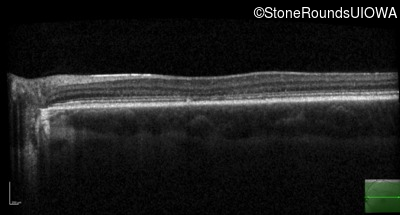
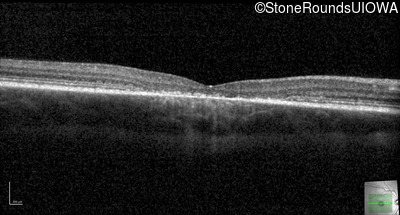
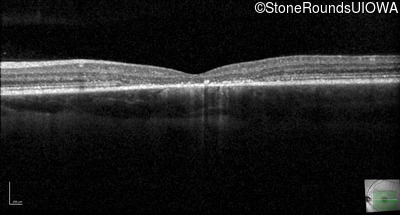
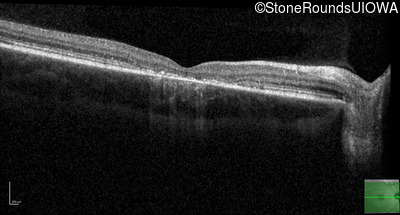
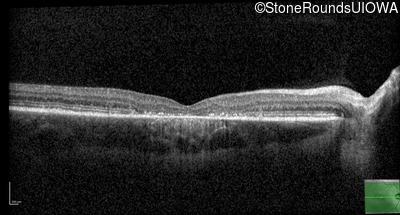
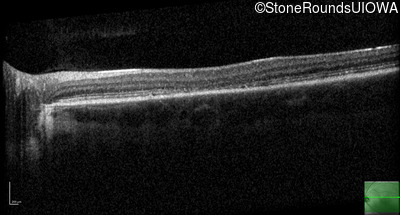

Case
SR502
Student Mode
AR Stargardt Disease (IIA)
Male
Male
Hidden
SR502
Student Mode
AR Stargardt Disease (IIA)
Male
Male
History
This 13 year old male first had difficulty reading print and road signs in the past year.
| Age at visit: 13 years |
| Age at visit: 13 years (Visit 2) |
| Age at visit: 15 years |
| Age at visit: 16 years |
| Age at visit: 17 years |
| Age at visit: 18 years |
Diagnosis & molecular findings
| Disease | Gene | Allele 1 variant(s) | Allele 2 variant(s) | Inheritance mode |
|---|---|---|---|---|
| AR Stargardt Disease | ABCA4 | IVS38-10T>C | Arg1108His CGC>CAC | AR |
Disease:
Gene:
Allele 1:
IVS38-10T>C
Allele 2:
Arg1108His CGC>CAC
Inheritance:
AR